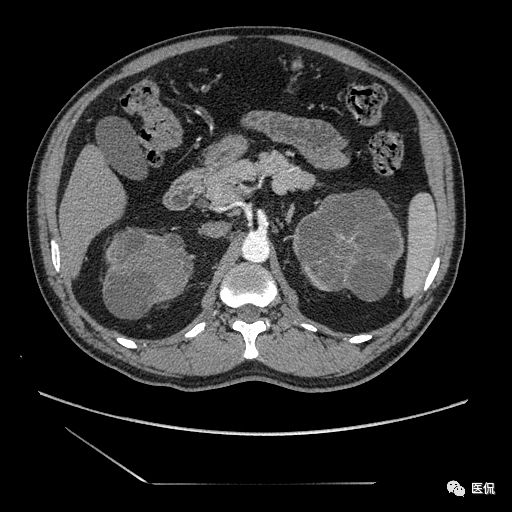
肾功能不全双肾回声稍增强怎么办,肾ct检查双肾萎缩

来源: 医侃
商务合作:2519330936@qq.com
患者信息
男,年龄:46岁
主诉:肾功能不全20余年,查血肌酐略高于正常,无明显尿频、尿急、尿痛,无肉眼血尿,无明显腰腹部疼痛。查体左肾区叩击痛(-),右肾区叩击痛阳性,双侧输尿管移行区压痛阴性,膀胱区无膨隆,未扪及包块,无压痛。
影像检查

小编留言:这些患者是别人的,但这些症状你工作中也可能会遇到,学习才是前进的唯一路径,有思考才有进步哦!
请做出你的诊断
A、双肾多发单纯性囊肿
B、多发囊肿性肾
C、多囊肾
D、多房囊肿性肾肿瘤
1
结果
多囊肾;
2
影像表现
双肾实质可见多发囊性密度灶,其内密度不均匀,并可见钙化灶,增强扫描未见明显强化灶。肾周脂肪间隙清晰,与邻近组织分界清楚。
病例要点
成人型多囊肾为常染色体显性遗传性疾病,其病理基础为胚胎时集合管壶腹部或/和间质部分支异常和囊性扩张,使内层肾单位与集合管未接通,尿液不能排出,使肾单位各段均可胀大成囊状。
多囊肾的 CT 表现主要表现为双肾增大,轮廓光滑或有分叶,肾实质内多个大小不等的囊肿呈蜂窝状,多呈水样低密度,增强扫描囊肿本身无强化,而囊肿间正常肾组织增强,对比明显。当囊肿张力过高,使囊壁上毛细血管牵拉破裂出血时,表现为囊肿内稍高密度影,随访CT 值减低。囊壁钙化,表现为点线状高密度影像,随访CT值无变化。有文献报道约 30%病例可并发多囊肝或多囊胰。
鉴别诊断
(1)双肾多发单纯性囊肿:CT平扫显示肾实质内圆形或椭圆形低密度灶,分界清楚,增强扫描无强化,囊壁薄而难以显示。囊肿数量少,无肾功能衰竭和高血压倾向。
(2) 多发囊肿性肾:虽在CT 上呈全肾由无数大小不等的水样密度的肿块组成,但在增强后见不到有功能的肾实质。
(3)多房囊肿性肾肿瘤或多房性肾囊肿:CT 特点是有厚间隙分隔的单个或多个充满液体的囊肿,伴有环状、星型或颗粒状钙化,其发病年龄呈双极性,婴儿和儿童以男性多见,成人则以女性多见,且此为少见病变。
【版权声明】本平台属公益学习平台,转载系出于传递更多学习信息之目的,如有图片、内容等不想转载传播可与我们联系删除。
【好书推荐】
《儿童间质性肺疾病》
临床影像病例图谱
原价160元限时特惠价116.8元
点击下方“阅读原文”立即抢购!